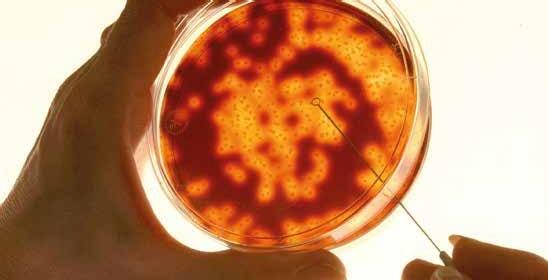

![]()


The theme of this year’s Annual Report is ‘what matters’, a theme chosen because – in a year of mixed fortunes – we can confidently say that in 2024-25 we focused on what matters to our supporters and the people we are here to support.
In many ways, this was deliberate as we set about realising our strategic aims of fighting to defeat meningitis in the UK within a generation, of reaching out to everyone who needs help, support and information, and of being recognised as a centre of expertise for aftercare and support.
For example, we launched our ‘No Plan B for MenB’ campaign to raise awareness of the risks of MenB and to protect current and future generations of young adults. We adopted a new focus on raising awareness of meningitis amongst sixth-formers, working collaboratively with our supporters and the PSHE Association. And we were delighted to have worked closely with NHS England in the implementation of Martha’s Rule.
At other times, our focus was more reactive. The calling of the General Election in July prompted the rapid publication of our ‘Manifesto for Meningitis’, which identified seven key changes that a prospective government could implement to make a real difference to our supporters. This included changes to vaccine policy, clinical culture and practice, scientific research and development, and support for the World Health Organisation’s global plan to defeat meningitis. In the months since, we have continued to advocate for positive changes to health and care, not least as the Government embarks on its new 10-year health plan.
A challenging economic year also meant that we had to adapt the charity’s financial management in both proactive and reactive ways. We invested in new charitable activities and initiatives, whilst also seeking savings and efficiencies – such as downsizing our office at Fern House, a decision that will save over £120k over the next five years.
Financially, 2024-25 was a mixed picture. Income at £2.147m was static compared to 2023-24, as funds that had been anticipated in the final quarter of the year either did not materialise or slipped into 2025-26. With expenditure at £2,573k, our deficit was therefore greater than originally budgeted at
£397k, compared to £297k in the previous year. Fortunately, our reserves enabled this deficit to be absorbed, but in 2025-26 the charity is obliged to realign its financial plans to return to balance sooner than originally planned.
Thankfully, the generosity of our supporters leaves us in awe, and we are grateful for the many thousands of individuals, families and organisations who supported us in 2024-25. This ranged from the amazing ‘Walk for Lloyd’ community who walked the Lake District’s 214 Wainwrights to raise £18,000 in memory of Lloyd Sutton, to many people who support us with regular direct debits or by kindly leaving a gift in their Will, to many companies and philanthropic organisations who provide invaluable grants, donations and funds. And, of course, our work in 2024-25 was made possible by our incredible network of volunteers, who continue to support our activities in their communities across the UK. We are grateful to all who supported us in 202425, some of whom are mentioned throughout this report.
What drives our charity, of course, is the ongoing incidence of meningitis in the UK. In 2024-25, data from the UKHSA showed that cases of the disease continued to rise within unvaccinated groups of the population following a lull induced by the Covid-19 pandemic. At Meningitis Now, we know only too well the pain and the devastation that disease can cause. This is why our mission of saving lives and rebuilding futures continues to be at the heart of what matters to us.
Thank you for taking the time to read this report.



Dr Tom Nutt Chief Executive
Chris Philipsborn Chair of Trustees
Our vision is a future where nobody in the UK loses their life to meningitis and everyone affected has the support they need to rebuild their lives.
We’re working towards making this vision a reality through our current strategy – 'making a difference, every day'. This means we strive to:

Fight to defeat meningitis in the UK within a generation

Reach out to everyone who needs help, support and information

Be recognised as a centre of expertise for aftercare and support

Our incredible London Marathon runners raise in excess of £170,000 for Meningitis Now.

CEO Tom takes part in an NHS conference on ‘Worry and Concern’ pilot projects, which aim to ensure seriously ill people, and their carers or loved ones, are listened to by doctors and nurses.
November 2024
436 supporters join us at our Gloucester Cathedral Carol Concert , a moving and uplifting evening. The centrepiece is our tree adorned with white ribbons, remembering lives lost to and changed by meningitis – part of our annual Ribbon Appeal, which is supported by 386 people, raising just under £12,000 in 2024.


25 supporters who have lost loved ones to meningitis come together for a Forever Weekend in Doncaster. Meningitis Now continue to provide invaluable bereavement support in 202425, working with bereaved families and individuals across the UK.
We mark World Meningitis Day by ‘lighting the tracks ahead’ with Great Western Railway (GWR). The special ‘meningitis train’ ran from Cheltenham to London Paddington, with a range of supporters on board, sharing their meningitis experiences with journalists. We achieve brilliant coverage on both BBC and ITV News.

We bring together 31 people for a Family Day at the Winchester Science Centre and Planetarium. These important support events give children the chance to be children – and give parents the chance to meet other families who understand how tough life after meningitis can be.

11 people join us for a Keep Connected online event for people experiencing fatigue after meningitis. One attendee said, "This was one of the most validating and uniting experiences I’ve had on this journey.” We ran four Keep Connected events in 2024-25, providing vital support for people navigating life after meningitis.
Bev Corbett leaves Meningitis Now after seven years as Director of Information and Support, but not before developing a new research strategy that ensures research remains at the heart of Meningitis Now’s work.

We launch new teaching resources with the PSHE Association, to give young people vital lifelong skills to make informed choices about their health, seek urgent care and remain healthy. The materials are created with supporter Sue Astley Theodossiadis, in memory of her 25-year-old son Alex, who died from meningitis in January 2020.

We hold our Midsummer Party at the Mall Galleries in London. Centred around a private viewing of the annual exhibition of the Society of Women Artists, this was a wonderful chance to gather and celebrate the work of Meningitis Now.

Thanks to our first national recruitment campaign, we recruit 45 new volunteers, who will raise vital awareness in their communities across the UK.
1,400 walkers take on the Five Valleys Walk , raising an incredible £54,000 by walking the fabulous 21mile route around the Stroud valleys.

UKHSA publish new figures, showing a rise in meningitis cases, following a lull in cases caused by the Covid-19 pandemic. Our CEO, Tom, appears on BBC Breakfast to discuss the risks of meningitis – joined by Sue Astley Theodossiadis, who lost her son Alex to meningitis. Supporters sharing their experiences remain vital to raising awareness of meningitis.

Our Rebuilding Futures Fund panel meet throughout the year, providing financial awards to 62 people –totalling over £53,000. Our financial support continues to change lives, funding specialist equipment, funeral costs and counselling in 2024-25.


A s the General Election is held in the UK, we publish our ‘Manifesto for Meningitis’ – outlining seven things Meningitis Now would like to see from the new government. We continue to shape and influence Government whenever possible, such as through a submission in December 2024 to the 10-year health plan consultation.

Our student campaign launches with a press campaign that reaches 50,000,000 people through 196 pieces of media coverage across TV, radio and print. We send 58,598 awareness materials to 58 universities and other organisations, also reaching nearly 422,000 people via social media.
We launch our No Plan B for MenB campaign, calling for more people to be protected against MenB and receive the lifesaving MenB vaccine on the NHS.

We are awarded the Patient Information Forum (PIF) TICK accreditation quality mark for our health information – showing we create meningitis information people can trust.
12 young people attend our Believe & Achieve residential. 90% of those who attended felt more confident after the event, with one attendee saying “I always thought that an independent life was something I would never have. After coming away [to the residential], I can see how this could be something in my future.”
• Campaigning for the MenB vaccine to be more widely available
• Being part of the conversation with the NHS, government and policy makers
• Developing a strategy that keeps research at the heart of what we do
MenB is one of the most common causes of meningitis in the UK. MenB kills and changes lives forever. Its impact is devastating, cruel, life-changing – and preventable. That is why in March 2025, we launched a new campaign –No Plan B for MenB.
We have effective, lifesaving vaccines against MenB, and vaccines are the only way to prevent meningitis. For those most at risk, there is no plan B for MenB. We must vaccinate those most vulnerable to protect them – now. And with cases of MenB on the rise amongst young people, following the Covid-19 pandemic, we must take action.
Our campaign is calling for three things:
• The MenB vaccination to be given to all those at most risk of disease.
• A MenB booster programme to protect adolescents from 2030.
• Availability of the MenB vaccination on the high street at a fair price.
We launched this campaign in March 2025 to our supporters, asking them to support us by sharing their experiences of MenB, so we can highlight the devastating impact meningitis has. This campaign will be a central part of our work in 2025-26, with plans to launch a petition, engage policy makers and keep MenB on the national agenda.


One of the thousands supporting our No Plan B for MenB campaign is Kate Speirs, whose daughter Sophia, 19, fell ill in 2023.
Kate told us: “Sophia was admitted to hospital whilst she was in her first year at Manchester University. She had spent a day vomiting and feeling very ill with a high temperature and flu-like symptoms.
“It was only when I Facetimed her and saw her jaw wide open and eyes glazed over, that I raised the alarm. She was unable to speak or move.
“It is so important for me to share this story because all this could have been avoided if she had been given the MenB vaccine. She received every vaccine that was offered to her within the NHS vaccine programme, including the MenACWY vaccine at school when she was in Year 9. Babies have been offered it (the MenB vaccine) on the NHS since 2015, so those who were born before that will not have been offered it.
“We were unaware, as so many others are, that MenB is a different vaccine that the NHS don’t currently offer to teenagers. And yet it is the cause of 9 out of 10 cases of meningococcal meningitis in the UK.”

It was only when I Facetimed her and saw her jaw wide open and eyes glazed over that I raised the alarm. She was unable to speak or move.
Sophia's mum, Kate

We continue to work collaboratively with a range of partners to influence policy and practice –and to promote meningitis awareness. In 2024-25, this has included:
• Contributing to The Partnership for Change: CEO Tom Nutt was one of ten patient organisation representatives brought together for The Partnership for Change initiative, exploring the challenges patients face across the health system, and calling for reforms to the NHS needed to create more joinedup, person-centred coordination and care. Read more about The Partnership for Change’s report, ‘Connected Care: Transforming Care Coordination’ on our website.
• Attending Pharmacy in Practice conference: Tom was part of a panel discussing the risks of antimicrobial resistance, the importance of community pharmacists promoting awareness of meningitis and the essential role of vaccines.
• Attending an AMRC and ABPI event: We were part of a joint Association of Medical Research Charities (AMRC) and Association of British Pharmaceutical Companies (ABPI) event on promoting diversity and inclusivity in clinical trials.
• Speaking at The King’s Fund conference: Tom was invited to speak at a session, focusing on ‘how to build effective partnerships between health and care and the life sciences industry.’ Meningitis Now have always worked closely with companies, such as GSK and Pfizer, and it was valuable to be able to explore this important issue.
• Taking part in Martha’s Rule conference: Tom took part in an NHS conference celebrating the successful conclusion of the ‘Worry and Concern’ pilot projects and joined NHS England’s new ‘Martha’s Rule’ Programme Board. We have been focused on improving the diagnosis and treatment of meningitis since 2018, when the report of the ‘Meningococcal Working Group’ was presented to then secretary of State for Health and Care, the Rt. Hon. Jeremy Hunt MP.
• Manifesto for Meningitis: With the General Election announced for July 2024, we presented our manifesto for what we wanted to see from the new government. Heading our list, was a commitment to make lifesaving vaccines available on the NHS to everyone in the UK who would benefit, and leadership to ensure that the UK’s vaccination and immunisation programme remains one of the best in the world.
• Supporting the World Health Organization: We also fully backed the World Health Organization’s (WHO) initiative to eradicate meningitis by 2030. We were a co-signatory to a commitment organised by CoMO, the worldwide Confederation of Meningitis Organisations, to bring together global voices of people affected by meningitis.

December 2024 saw the departure of our Director of Information and Support, Bev Corbett. During her seven years in post, Bev played a pivotal role in our fight to defeat meningitis and provide support to those impacted by the disease. Our new Director of Information and Support, Sue Rogers, will be joining the team in April 2025.
Before she left, a key priority for Bev was developing our research strategy. Research remains at the heart of what we do, and our revised research strategy derives from our vision of a future where no one in the UK loses their life to meningitis, and everyone affected gets the support they need to rebuild their lives.
Meningitis Now has funded scientific and medical research into meningitis and meningococcal disease over the last four decades. In many cases, this research has advanced the charity’s aims and objectives by hastening and improving the development and deployment of vaccines – and by improving scientific and medical understanding of meningitis, its causes, treatment, after-effects and impact.
Our new research strategy ensures this legacy will continue and identifies two key research areas:
• Improving quality of life – undertake research that looks at long-term outcomes and improves the quality of life for individuals and their families who have experienced meningitis.
• Understanding lived experience –gather data on people’s lived experiences of meningitis and real-world outcomes to provide insights that can guide future research and inform best practice. We will ensure that those affected, including families and caregivers, have opportunities to contribute to the research agenda, influencing areas that directly affect their lives.
As a member of the Association of Medical Research Charities (AMRC), it helps ensure we work to recognised standards of best practice and within the AMRC’s guidelines.
and recently completed research projects
Developing a multivalent Streptococcus pneumoniae recombinant glycoconjugate vaccine for preventing meningitis
University College London
Professor Jeremy Brown and Professor Brendan Wren, of University College London’s Department of Respiratory Medicine, have been leading on this three-year project.
The research team has developed a new technique that has the potential to produce cheaper vaccines that protect against more strains of pneumococcal bacteria, including those that cause pneumococcal meningitis.
Understanding survival and adaptation of the meningococcus bacteria in aerosol droplets
University of Bristol PhD candidate Mia Dierks Treece, and supervisor Dr Darryl Hill of the University of Bristol, aim to understand more about how meningococcal bacteria survive and adapt during transmission from human to human in aerosol droplets. Understanding more about meningococcal bacteria could one day help us improve how we prevent, diagnose and treat meningitis.
Meningitis Now is funding a four-year studentship for Mia, who presented her findings so far at our all-staff meeting in February. These included that the survival of meningococcal bacteria in the air partly depends on humidity. The team has also begun to unravel the mechanisms that cause this bacteria to die in the air.
SURE + DP: Improving diagnosis and prognosis for paediatric tuberculous meningitis through the SURE treatment trial
University College London & London School of Hygiene & Tropical Medicine
A team based around University College London and London School of Tropical Medicine is carrying out this research.
Tuberculosis meningitis (TBM) is the most severe form of TB, killing 20 - 40% of people affected and leaving many survivors with lifelong disabilities. Young children are particularly at risk. This research is running clinical trials to improve the diagnosis and treatment of this type of meningitis.
• Raising awareness, with a focus on young people
• Reaching new audiences through traditional and digital channels
• Creating meningitis information people can trust
This year, we worked with the PSHE (Personal, social, health and economic) Association and Meningitis Now supporter Sue Astley Theodossiadis, to launch new teaching resources. These resources will give young people vital lifelong skills to make informed choices about their health, seek urgent care and remain healthy. They have been produced in memory of Sue’s son Alex, who sadly died from meningitis aged 25.
Alex was living away from home and hadn’t registered with a local GP. When he became unwell, he struggled to gain access to healthcare services quickly – it took three separate attempts over five days to finally be diagnosed and treated for meningitis, by which time it was too late.
We were pleased to work closely with Sue and the PSHE Association on developing resources and preparing them for publication. Focus groups with sixth formers were arranged to make sure the materials were appropriate and relevant. The resource consists of two lessons, which teach 16 to 18-year-olds how to recognise serious illness in themselves and others, and to have the confidence and knowledge to navigate the healthcare system. One section includes role-playing on how to get a doctor’s appointment.
Sue said: “My hope is that these teaching resources will help prevent others dying in a similar way. All healthcare professionals, and GP receptionists, need to be aware of the difficulties young people can have in explaining themselves.”
Sue also shared Alex’s story as part of our Ribbon Appeal and at our Christmas concert in Gloucester Cathedral.

The pack has been funded by Meningitis Now and the Faculty of Biology, Medicine and Health at The University of Manchester, where Sue works.

Our annual student awareness campaign this year focused on asking students, universities and parents: Do you know when to sound the alarm?

• 58 organisations, including 44 universities, requested our information materials.
• Nearly 50,000 signs and symptoms cards were ordered, alongside thousands of other promotional and awareness materials.
• Best-ever media reach of 390,574,007 with 196 items of press coverage, including BBC Breakfast, with a total value of £54,151.
• Radio coverage campaign resulted in 192 pieces of coverage, reaching 50,000,000 listeners.
• A new webpage received 5,188 views.
• Social media reach was 421,889, a video on TikTok was viewed nearly 11,000 times.


We plan to build on the impact of this year’s ‘sound the alarm’ messaging with our 2025 student campaign. Thank you to ‘a Life for a Cure’ who continue to fund this vital work.
In 2024-25, we also started to focus on raising awareness amongst sixth form and college students. It is vital to raise awareness of meningitis with this audience before they leave home and start university – and whilst they are still in further education, they are perhaps a more captive audience than university students.
Thanks to a grant from GSK, this year we have begun producing a new awareness video, as well as other digital assets and physical materials to raise awareness at sixth forms


and colleges across the UK. The materials will be distributed by our UK-wide network of volunteers. This project is due to launch in July 2025, and we look forward to sharing details of its impact in next year’s report.


Each year, we work collaboratively with the charities Meningitis Research Foundation and a Life for a Cure, alongside the NHS and the UK Health Security Agency, on an awareness campaign funded by GSK. The ‘Roundtable on Meningitis Awareness’ produces a Tackle Meningitis website and social media campaign, which this year ran in January 2025.
This year’s campaign, also featured a media day with ex-England rugby star Matt Dawson and Paralympian runner Jonnie Peacock in June, to promote the Tackle Meningitis website and to raise awareness of meningitis risk.
The theme for this year’s World Meningitis Day was ‘lighting the road ahead to a future free of meningitis’. We marked the occasion by ‘lighting the tracks ahead’ with our corporate supporters, Great Western Railway (GWR). A special meningitis train service ran from Cheltenham Spa to London Paddington, calling at Stroud, where our head office is based.
On board, Meningitis Now supporters shared their meningitis experiences with journalists and highlighted the importance of the day.
At stations along the line, volunteers collected donations while raising awareness of meningitis and its symptoms, and explained the support available from us.
The special train arrived at London Paddington just before midday to be greeted by charity supporters and Meningitis Now president, TV and radio presenter Lisa Snowdon.
On Saturday 5 October, we joined organisations across the world in lighting up buildings and landmarks to mark World Meningitis Day. HSBC in Birmingham lit up their Head Office, and GWR and Network Rail lit up Paddington Station at 8.30pm in our corporate orange colour to help raise further awareness, as part of the worldwide movement to defeat meningitis.

New data released by the UK Health Security Agency (UKHSA), which is responsible for public health protection in England, showed that MenC disease is down by around 96% since 1999, when the vaccine was first introduced to the NHS routine vaccination programme. Cases of MenC, MenW and MenY are also reported by UKHSA as being very low because of the teenage MenACWY vaccine programme.
We welcomed the news that the MenACWY vaccination programme is having a positive impact on the number of cases, and worked with the UKHSA and supporter Becca Heritage to help publicise the findings. Her story was widely covered in the national and regional news media.
Becca, from Southampton, contracted meningitis when she was 19, leaving her with life-changing after-effects.
“Six weeks after starting at the University of Southampton, I contracted meningococcal septicaemia in November 2018.
“I felt slightly unwell, a bit like a hangover, but was vomiting continuously, so went to A&E. I was about to be sent home when I collapsed and started showing signs of sepsis. A few hours later, I was put in an induced coma and moved to intensive care. I was in the coma for two weeks, during which my family were told to prepare for the worst, twice.
“Fortunately, I came out the other side but faced permanent after-effects. I spent nearly four months in hospital and several more recovering at home.
“I lost both my legs below the knee and fingers on both hands. I spent seven weeks in rehabilitation when I was discharged from hospital, learning to walk on prosthetic legs.
“I was fortunate to receive a hand transplant in Leeds last year, which has been absolutely amazing! I have much more function so far, and I am still doing physiotherapy to help improve this. I am also gaining sensation in my new hand now, so I can feel warmth, cold and some textures.
“Although my life has a new ‘normal’, I’m very grateful that I am back to uni and living my life! Everything is going well, and I hope to graduate in 2027 as a doctor.

“The support my family and I received from Meningitis Now at one of the hardest times was amazing. They offered a range of types of support including counselling and peer support through their Believe & Achieve programme for young people.
“We are now keen to help support other families affected by this disease.”
We were delighted to receive the Patient Information Forum (PIF) TICK accreditation quality mark for our printed and digital health information. The PIF TICK is the only independently assessed quality mark for printed and digital health information. Many health charities and NHS organisations use it as a mark of trusted health information.
To become a ‘trusted information creator’, we had to undergo a stringent assessment, showing we met 10 key criteria, covering such areas as systems, training, need, evidence and transparency.
With misinformation rife, it has never been more important for Meningitis Now to produce accurate, trustworthy and easy to understand information. Our PIF TICK shows we are doing this, but our work on our digital platforms is also essential to ensure this information reaches as many people as possible.
There have been real challenges in this area in 2024-25. In January 2025, Meta brought in new rules for all health charities, affecting the way our website and Meta platforms like Facebook and Instagram interact.
In August 2024, Google introduced AI overviews – creating AI-generated overviews of information when people search, rather than showing them websites where they can find that information. We have to change the way we work to ensure that our accurate information is included in as many of these searches as possible.
We also have concerns – shared by many other charities and organisations – about the dangers of AI overviews, which often draw on inaccurate information. Combatting this kind of misinformation will be a priority for us in 2025-26.

•Providing a range of life-changing and impactful support services
•Helping people navigate life after meningitis and find their new normal
•Creating communities through the support we provide
With nearly 40 years of experience, Meningitis Now is leading the way in meningitis aftercare and support.
We’re doing this by:
• Providing information people can trust
• Providing vital support services
• Informing best practice to improve the lives of people affected by meningitis
Our unique support team provides an impactful package of support to anyone affected by meningitis across the UK. We work with multiple partners and health organisations to develop educational materials to increase awareness of meningitis, promote the importance of vaccination to support public health and deliver high-quality aftercare and support – providing an invaluable lifeline for thousands of people and their families each year.
During 2024-25, we had 1,738 unique contacts to our nurse-led Helpline. Of these, 1,269 were first-time callers. Many of these people will require several weeks of support, advice and guidance before they have the information and confidence necessary to navigate their journey or to access our wider range of support, including one-to-one personalised support with our community team across the UK.
Thank you so much. I am so grateful. You have given me a lot of information, and it’s incredibly helpful. It’s put my mind at rest and given me a lot of comfort.
Helpline caller
This year, we allocated over £53,000 of funding through our Rebuilding Futures Fund, supporting 62 people through our unique programme of financial support. And 118 callers went on to have one-toone support from one of our Community Support Officers across the UK.
Thank you so much for being there. I feel listened to and supported. The two nurses I have spoken with in the past few months have been excellent and provided me with really helpful information.
Claire, whose daughter contracted meningitis at one-day-old.
Of those who completed our post-call user survey this year, 100% rated the information we provided as very useful, and 91% said they felt more confident in dealing with the issue.

This year, we spent nearly 30,000 minutes supporting 490 people, providing vital emotional, practical and financial support completely free of charge.
Our Rebuilding Futures Fund has helped to create a private remembrance garden for a young girl who sadly lost her mother to meningitis five years ago.
Grandfather Paul told us: “In February 2020, we lost our daughter to this cruel disease at the age of 35. She left behind an eightmonth-old baby girl and a heartbroken husband and family.
“Recently our granddaughter started asking questions about why she couldn’t visit a grave for her mummy and place flowers there as her friends at school do when they visit their grandparents’ graves. There is only a book of remembrance at the crematorium.
“We came up with the idea of creating a memorial garden for our granddaughter at home, where she could spend time and have quiet moments to reflect.
“We created the garden with Meningitis Now’s help, putting down some hard stone, getting a birdbath (a robin often visits the garden) and providing a pot with a rose named after our daughter. There’s also a bench with an engraving of her name, and a tree that sits with her mummy’s ashes in the pot in the garden.
“The award has made a huge difference to the whole family, and it is a place where we can all sit and reflect, which really helps us all. We are so grateful to receive this award. It has helped us to create a wonderful place for our granddaughter to remember her mummy.
“It brought a tear to my eye when I heard that our application had been successful.”

We came up with the idea of creating a memorial garden for our granddaughter at home, where she could spend time and have quiet moments to reflect.
Grandfather, Paul
Over the year, our support team organised a range of in-person and online support events, creating opportunities to connect, share experiences and build community. The team provided five online and four in-person events.
These included a number of events with our popular Believe & Achieve programme for young people affected by meningitis and an online support event for adults who have hearing loss.
We are so grateful to have the support of the Meningitis Now charity. It has been a helping hand to us for support and offers an outlet to meet other families in a similar situation. It is like a family who are always there for each one of us on the darkest of days.
A
In March 2025, 12 young adults with an experience of meningitis enjoyed a residential experience at Center Parcs, Woburn Forest –an opportunity for adventure, connection and personal growth.
The weekend included an indoor climbing adventure and an escape room challenge; both designed to stretch comfort zones and build trust.
A group life-coaching session on Sunday morning created space for reflection and time to think about personal and professional aspirations for the future. Guided by skilled coach Lou, young adults were invited to consider where they are now and where they want to go – learning how to create a stepby-step plan of action and using powerful questions to unlock skills.
Perhaps the most important part of any Believe & Achieve event, is the power of shared experiences, and the comfort found in sharing and listening to each other’s personal stories. It was clear that being heard, and hearing others, in a safe space with no expectation or judgement, was just as transformative as climbing a rock face or solving a puzzle.

In September, we hosted an online support event for adults who have hearing loss after meningitis and for parents and carers of children who have hearing loss as a result of meningitis. We were delighted to have Rebecca Mansell, Chief Executive of the British Deaf Association, join us for this session.
Rebecca, who had meningitis aged four, shared her personal experience of living with hearing loss after meningitis and talked about some of the work the British Deaf Association do to empower deaf people.
After the event, attendees overall felt more confident in managing their hearing loss. One
told us: "I have profound hearing loss in one ear, and moderate hearing loss in the other. It's good to know that I am not alone in this, and it was good to hear some inspiring stories.
Other online support events we ran in 202425 include ‘Managing fatigue after meningitis’ (December 2024) and a six-week anxiety management course (March 2025).
We had a range of supporters join for the event and it felt great to be able to create an environment that was inclusive to everyone’s needs.
Our Community Support Officer, Ellie

It was such a good experience and nice to have a break where you’re understood without explanation. I will remember the open conversations and people being comfortable to share.
Believe & Achieve event attendee
Whilst 2024-25 was a successful year for fundraising and volunteering at Meningitis Now, it was not without its challenges. The changing post-pandemic landscape of fundraising, the cost-of-living crisis, and political uncertainty all impacted our ability to raise funds. We were aiming for fundraising growth in 2024-25 but ended the year in a comparable position to the previous financial year.
However, although we fell just short of our total income target, the charity still finished in its strongest financial position since the Covid-19 pandemic. Our wonderful supporters helped us raise £2.147m in 2024-25, and we remain incredibly grateful for their amazing support.
Incredible supporters doing incredible things for Meningitis Now
Eye-catching fundraising events this year, included supporter Scott climbing Mont Blanc, inspired by his daughter Noa Rose. Ben and Bertie unicycling from London to Bristol. And the Walk for Lloyd team conquering all 214 Wainwright Walks, raising over £18,000 along the way in memory of Lloyd Sutton.
Josie completed a wing walk, whilst 1,400 of you kept your feet firmly on the ground for our Five Valleys Walk, raising over £54,000. The Cycle for the Vicar group pedalled all the way from Paris to Somerset. And Laura Barley was one of 131 people who took on our Squats Save Lives Facebook Fundraising Challenge, together raising a massive £17,800.

Olivia and a team of family and friends walked from her home to the hospital that saved her life, and raised an amazing £4,000, whilst long-time supporter Julie Fleming pulled out all the stops to reach £30,000 through her daughter Jessica’s Forever Fund – with a range of fundraising events themed around the figure 30. Hundreds of you joined us at our London and Gloucester Carol Concerts. And Team Alexis Rose continued their amazing programme of fundraisers and have now raised an incredible £135,000 to support the fight against meningitis in the UK.
Thank you one and all – and all those too numerous to mention here – for everything you do and continue to do.







This year’s London Marathon team raised an impressive £174,000 for Meningitis Now. One of those to take on the challenge was Paul, who was running in memory of his stepdaughter, Rhiannon.
“I ran my first marathon just before my 50th birthday and got a bit of a bug for it. I thought I’d do one marathon every year and this was my last. I turned 60 on the day of the race and for this marathon, I’ve raised almost £5,000 for Meningitis Now.
“What started us on the fundraising journey was the support we had from Meningitis Now from day one after Rhiannon passed, and we continue to get. My wife still gets a phone call from a Community Support Officer at least every couple of months to check in.
“We’ve been on Forever Weekends, and we just felt that we wanted to raise awareness of meningitis, so people know what the symptoms are and can take action quickly. We also wanted to give something back to the charity, so they can support other people going forward, other families like us.
“The London Marathon is such an amazing course with great landmarks to see and fantastic support from the crowds. My race went really well – I was buzzing and proud of my achievement.
"Rhiannon's memory is my true inspiration together with the awesome support we have had from people during my fundraising efforts.”
We’ve been on Forever Weekends, and we just felt that we wanted to raise awareness of meningitis, so people know what the symptoms are and can take action quickly. We also wanted to give something back to the charity, so they can support other people going forward, other families like us.
Paul

We would like to thank our amazing funders and supporters for their generosity in 2024-25. Many companies showed their support during the year, including:
• Brewin Dolphin, whose West of England team have chosen us as their Charity of the Year.
• CORE Special Projects Ltd, who raised a fantastic £2,380 through their golf day in June. Sarah-Jayne Beckett and Sarah Spyvee at CORE also completed a skydive in September. The team have now raised over £5,000 for Meningitis Now in memory of Pete Hynes.
• The team at Caroline Gardner Publishing for donating over £9,400 from the sale of their Christmas cards and for joining us to cheer on our runners at this year’s London Marathon.
• The team at Quayside Wealth Management who raised funds in June by running the Swansea Half Marathon with our CEO Tom. They were joined by staff from Tayntons, Leaders Romans Group and Miint Marketing.
• The Fays Flowers team for hosting a Mother’s Day competition for us, with the lucky winner winning a three-month flower subscription.
• GSK for their donation of £20,000 towards our awareness work with sixth forms and colleges.
• Alison Eddy, a Meningitis Now Business Ambassador, and the team at Irwin Mitchell Solicitors for renewing their support as one of our Brighter Futures Partners, with a donation of £5,000, as well as additional generous sponsorship during the year.
• The teams at Irwin Mitchell and Enable Law for taking part in May Mayhem to raise vital funds and awareness.
• Nationwide, Ripley, for donations totalling over £500, including their recent Valentine’s Day, Mother’s Day and Easter hamper raffles.

• Easement Solutions Limited for all their fundraising efforts this year raising over £1,300 in memory of baby Teddy. A particularly big thank you goes to Jason Everett, who took on a 150-mile bike ride in one day, raising over £500.
• Institute of Cemetery and Crematorium Management for a wonderful £11,600 towards our work.
• Longstanding supporter, Renishaw, for agreeing to be the headline sponsor of this year’s Five Valleys Walk.
• Bluestone Insurance Services for sponsoring our Five Valleys Walk for a second year running.
• Tigerbond for climbing Scafell Pike and taking on the Three Peaks Challenge in memory of colleague, Rhiannon.
• Source Group International for hosting a golf day in July to raise vital funds in memory of Primrose Adey.
• Hometrack team, who walked 10k steps a day throughout May and raised over £2,000.

Students and staff from King Edward VI School (KES) – William Shakespeare’s school in Stratford-upon-Avon – raised an amazing £26,000 towards our ongoing work, after we were selected as their Charity of the Year.
We were nominated by two A-level students, Katherine and Job, who have both seen the impact meningitis can have on loved ones.
Katherine said: "Following the death of my grandma due to meningitis, my family received support from Meningitis Now, which helped us a lot. I became an ambassador for them, and through this, I have learned more about the disease and what the charity does in terms of raising awareness.
Knowing both how vital the charity’s work is in saving lives and how close it was to both of our hearts, we are very grateful to have
successfully campaigned for it to be charity of the year at KES."
Job added: “My dad was hospitalised with the disease when I was four-years-old. Meningitis Now offered him support in order to aid his, fortunately, successful recovery.
“The charity's work in raising awareness about the disease is crucial, considering the symptoms are frequently ignored.”
Throughout the academic year, students have been holding a variety of fundraisers, including 24 in 24, which saw 100 students and staff run 4km every four hours for 24 hours. They also handed out our symptoms cards to spectators along the route of the annual Shakespeare Birthday Parade. KES headmaster Bennet Carr also did his bit, taking on the London Marathon for us.
Knowing both how vital the charity’s work is in saving lives and how close it was to both of our hearts, we are very grateful to have successfully campaigned for it to be charity of the year at KES.

A huge thank you to Bed & Bars, whose annual charity week raised awareness and an amazing £21,182 for Meningitis Now, accounted for in 2025-26.
Beds & Bars is a leading operator of tourist accommodation and entertainment venues in Europe, with backpacker hostels, bars and traditional British pubs in 12 cities and eight countries.
During 'Live Your Life Week', every profit made from three of their drinks was donated directly to us, and there was a special Meningitis Now themed drink on offer. Signs and symptoms information was also advertised around the bars.
The week culminated in parties at bars across the UK and Europe, decorated with Meningitis Now’s signature orange with balloons and posters. Live music and special cocktails encouraged more fundraising and was a fantastic way to end the week.
Turtle Tots teaches vital lifesaving skills, builds water confidence and creates special, fun-filled memories for babies and toddlers. Throughout the month of October, members of this awardwinning baby, toddler and preschool swim school once again took part in Splash Now – a week of sponsored water-based activities to raise vital funds for us.
The creation of Splash Now was inspired following the death of baby Clara, who tragically lost her battle with meningitis at just 10-months-old.
This was the fourth year that Turtle Tots have supported Meningitis Now. To date, their brilliant team have raised an incredible £86,773, including Gift Aid.
We would like to say a special thank you to Turtle Tots co-founders, Caroline Sparks and Gaby Lixton for choosing to support Meningitis Now and to the franchises and families who have taken part in this special event over the past four years.



In 2024-25, we received 15 legacy gifts and raised a significant £121,504 from Gifts in Wills. This is an important source of income for Meningitis Now, and behind each gift lies a powerful and emotional story.
Supporter Geoff Howse and wife Lynda told us:
The reason for Meningitis Now being a beneficiary of our Wills is to provide funds for research into meningitis vaccines, to help rebuild the lives of people affected by this disease and hopefully to stop families having to go through what I went through with my daughter Emma 25 years ago.
Emma lost her fight against the C strain of meningitis in 1999, aged just 15. What she would have done with her life we shall never know – we can only speculate.
Since then, the charity has been amazing to me and Lynda, Emma’s stepmum. We just want to give something back. Being involved with Meningitis Now for the last 25 years is the one good thing that came out of losing Emma.
That’s why Lynda and I have made Meningitis Now a beneficiary of our Wills. Hopefully our story will encourage other people to leave a legacy in their Will to Meningitis Now to fight against this disease in the future and help protect our children and families
In 2024-25, 1,558 people supported us through a regular gift – including Direct Debits, standing orders, giving through payroll and playing our lottery. Regular giving remains vital for Meningitis Now – allowing us to better future financial planning and raising £140,536 this year alone.
We were honoured to receive the support of 91 grant makers during the year. Ten of these funders were supporting the charity for the very first time. A huge thank you to all the charitable trusts and grant-making organisations who made life-changing donations to our work in 2024-25. These include:
Alice Faith Mittelman Foundation




Our Midsummer Party raises an incredible £18,600
Our first Midsummer Party at the Mall Galleries in London was a huge success, raising £18,600. Thank you to everyone who showed their support and made it such a special night.
The event, kindly sponsored by Irwin Mitchell, brought together our amazing supporters for a private viewing of the annual exhibition of the Society of Women Artists. Guests had the opportunity to win donated works of art, purchase one-off pieces and show their support for the charity.
During the event, two meningitis survivors had their art on display – Matilda Sharpley and Liz Curry.
Meningitis Now Trustee, Randy Weeks, led an exciting live auction of pieces that had been donated with 100% of the auction proceeds going to Meningitis Now.
A raffle was drawn by Rachel Parker, Vice President of the Society of Women Artists. Rachel’s daughter survived meningitis as a baby, and last year Rachel and her family took on the Richmond Air 10k to raise £5,000 for us.
The evening also featured a Q&A session with Believe & Achievers Erin and Charlotte, who did an amazing job sharing their experiences of meningitis.
I hope that through sharing my experiences, I can help someone else to feel less alone, to know what support is available, and to feel hopeful about their future.
Erin Jones

At Meningitis Now, we count ourselves fortunate to have a fabulous team of volunteers supporting our work and making a huge contribution to what we do. We have 195 active volunteers around the UK, tirelessly helping us to raise awareness of this devastating disease and fighting back against its impact.
Our volunteers help us raise awareness by giving talks, running stands and distributing literature. They also raise funds in street or supermarket collections – as well as helping at our big events like the London Marathon, Five Valleys Walk and our Christmas Concerts.
In June, we celebrated our volunteers during National Volunteer Week. Our CEO Tom said: “Quite simply, they are invaluable to us. They work as part of a fantastic team across the UK and bring a richness and diversity to our work. We simply couldn’t do what we do without your ongoing support, generosity and inspiration.
“Because of you, we are louder with our awareness messages, reaching more people who need us, making change happen, funding more research and, above all, getting closer to making our goal – where no one dies from meningitis and everyone affected gets the support they need – a reality.”
Volunteering has a positive impact on the volunteer as well as the organisation. Here are just a few of the many comments we’ve received from our volunteers:
In June 2024, we ran our first ever national volunteer recruitment campaign. Through email, newsletters and social media, the campaign resulted in 90 applicants and 45 successful new volunteers to date. We can’t wait to hear about the incredible ways these new volunteers will help us save lives and rebuild futures.

Meningitis Now has helped to transform a dark, frightening period of my life into an opportunity to make a difference and connect with incredible people.
I always enjoy volunteering and always come home feeling I've made a difference!
Volunteering for Meningitis Now is very rewarding and fun.
Our plans for 2025-26 include:
1

• Campaign for more young people to be protected against meningitis through our No Plan B for MenB campaign.
• Develop a new scientific panel, to support research development and current projects.
• Continue to work collaboratively with external partners including UKHSA, NHS, WHO and other charities and industry.
2

Reach out to everyone who needs help, support and information
• Expand our awareness raising with young people to focus on sixth forms and colleges, including a new student awareness video.
• Prepare to mark our 40th anniversary in 2026 through awareness and fundraising activities.
• Create a Participation Panel, consisting of volunteers with diverse lived experience of meningitis to inform our work.
3

Be recognised as a centre of expertise for aftercare and support
• Review and update our disease literature, including factsheets and signs and symptoms cards.
• Explore needs-based opportunities to develop our support offer, whilst continuing to deliver our existing wide range of services.
• Seek opportunities to work in partnership, strengthen our existing relationships and broaden our networks.
The charity set an ambitious budget for the year, making use of surplus reserves. With the challenging economic environment in 2024/25, income fell short of the budget target but remained roughly in line with the previous year overall. This has required bringing forward plans to use up surplus reserves and realignment of the five-year finance model to manage expenditure against income and ensure we continue to maintain our reserves target. At the year end, the charity’s reserves were within the target range set by the Reserves Policy.
Total income raised in the year, including gifts in kind, was £2,147k (2024: £2,157k). Gifts in kind were £185k (2024: £215k).
Total expenditure in the year was £2,573k (2024: £2,516k). We spent 69% (2024: 66%) on charitable activities, and 31% (2024: 34%) on raising funds. Expenditure on research was £110k (2024: £226k).
With the turbulence of the stock markets during the year, at 31 March our investments produced a gain of £28k and overall value of £778k. The original investment of £500k in April 2016 is held in a portfolio fund of Sarasin and Partners LLP.
Overall, Meningitis Now made a deficit of £397k (2024: deficit £297k). The charity had planned a deficit budget for the year, although the actual deficit was greater than the budget. This has advanced the plan to realign the income and expenditure budget in future years, with the charity proactively seeking savings whilst continuing to explore opportunities to grow income.
At the year end the charity held cash of £676k (2024: £1,155k) plus investments of £778k (2024: £750k).
Unrestricted reserves were £956k (2024: £1,170k).
The charity has continued to maintain and update its financial plans, recognising the impact of the current economic climate, ensuring it continues to operate as a going concern and is able to deliver its charitable objectives.
Meningitis Now’s wholly owned trading subsidiary, Meningitis Trust Trading Limited, was effectively dormant in 2024-25. There were no transactions in the year (2024: no transactions).
Staff continued to be our greatest asset in 2024-25. Headcount increased to 48.7 or FTE 37.6, from 42.4 or FTE 32.6 the previous year (as of 31 March). This year we:
• Continued our programme of staff engagement (entitled ‘Making Meningitis Now a Great Place to Work’), with our staff satisfaction survey showing overall ‘positive’ results year on year.
• Continued to develop our recruitment processes to deliver a positive and personalised experience for applicants, tailored to their needs.
• Delivered a varied wellbeing programme for staff and workshops for managers.
• Expanded our training programme, including new e-learning courses such as Neurodiversity and Sexual Harassment Awareness, and development sessions on topics such as Courageous Conversations in the Workplace.
• Continued the roll-out of cloud-based IT systems, including the introduction of VOIP (Voice over Internet Protocol) phones.
• Maintained our Cyber Essential Plus accreditation.
• Reduced our office space, and refreshed the layout, furniture and hybrid meeting equipment. Not only has this created a more pleasant and useable space for staff to work from and visitors to visit, but crucially it will also save the charity £120,000 over the next five years. We are hugely grateful to Abbey Business Interiors who helped us with this refurbishment.
In the context of a difficult economic environment, recruitment has at times been challenging and reduced team capacity has posed a risk to us achieving our plans. We took steps to mitigate the difficulties of recruitment, including reviewing starting salaries for key roles and targeting pay increases for key staff to support retention. As a result, we have made excellent appointments to the Support, Fundraising and Communications teams, including several remote roles.
EDI remained a top priority at Meningitis Now in 2024-25. This year, our EDI steering group achieved a number of things.
• We changed our EDI training programme.
• We published an EDI statement online.
• We adopted a new approach to photographs and photographic representation of meningitis and Meningitis Now, creating better image diversity.
• We changed our recruitment processes.
• We introduced a new mode of EDI monitoring.
Meningitis Now is based and operates in the UK, with its headquarters in Stroud, Gloucestershire. During 2024-25, we were governed by a Board of 12 (11 after October 2024) Trustees who met on a quarterly and needs-basis during the year. The Trustees operate with four sub-committees that review specialist aspects of our work or that undertake work on behalf of the full Board of Trustees: Audit and Risk, Investment, Remuneration, and Nominations.
Day-to-day running is delegated to the Chief Executive and the Senior Leadership Team. Budgets and plans are approved by the Board with performance subsequently reported against plans and budgets via Board meetings.
In determining our remuneration policies and practice, the Remuneration Committee takes into account all factors which are deemed necessary. The overall objective is to ensure that the CEO and staff team are remunerated in line with market rates for the skills, competencies and experience they bring. We operate a ‘Pay Review Panel’ comprising the CEO, Head of Finance and HR Manager which meets regularly and ensures that we remain responsive to factors such as pay, employment and market conditions.
Delivery of our charitable vision is primarily dependent on our staff, which is the largest single element of charitable expenditure. The annual cost of living award in 2024-25 was 3%, taking into account the customary factors of inflation and wage growth, pensions/NI and tax changes, affordability and organisational context.
There was one member of staff who earned between £60k and £70k and one member of staff earned between £80k and £90k (excluding employer pension costs) in the year. Further information on pension arrangements and on the salary costs for the year, with comparisons with the previous year, are presented in the notes to the financial statements.
No Trustees are remunerated for their role within the Charity, receiving only out-of-pocket expenses. A Conflicts Register is maintained to ensure no Trustees receive indirect remuneration for their involvement.
The Trustees have referred to the guidance contained in the Charity Commission's general guidance on public benefit when reviewing our aims and objectives and in planning our future activities. In particular, the Trustees considered how planned activities will contribute to the aims and objectives that have been set.
We have a clear Fundraising Policy, which has been approved by the Board and is reviewed annually (https://www.meningitisnow.org/support-us/who-we-are/data-protection/fundraisingpolicy/).
This governs how we work with funders, and whilst we actively seek to work with external organisations and individuals to achieve shared objectives, we recognise that it is vital that we maintain our independence and do not allow any external partnership to bring the reputation of Meningitis Now into disrepute.
Meningitis Now’s key principles of responsible fundraising are:
• We have honest relationships with our donors
• We retain our independence and avoid over reliance on one or more donors
• We have good processes for making decisions about who we accept money from
• We seek to be as cost effective as possible in developing sustainable fundraising income streams
• We will adhere to all Fundraising Regulator Codes of Practice to ensure best practice, transparency and accountability and are governed by part II of the Charities Act 1992
• We are registered with the Fundraising Regulator.
Over the last few years, the charity has held reserves above the upper limit set in its Reserves Policy. This has been kept under review with a deficit budget set as part of the plan to realign the position. In 2024, the Board reviewed and adopted a new Reserves Policy, moving to a risk-based approach and assessing free reserves. It is noted that the definition of free reserves are the total charity funds less restricted reserves and fixed assets. The charity’s policy is to maintain the following reserves:
• Restricted funds – funds that have been donated to the charity for a specific purpose
• General funds – being unrestricted funds available to meet the planned operating needs of the charity and to cover any unforeseen circumstance that the charity may face. The upper limit is set to meet the planned operating cash for five months with consideration of the risk of failing to achieve income targets; the minimum level is set at three months planned operating cash, with consideration of winding up costs of the charity should closure become necessary.
At the start of 2024-25, we had planned to use £104k of our reserves during the year. Due to the challenges of raising funds in the current economic environment, the net out-turn used £397k from reserves.
Using our new Reserves Policy, the target free reserves was £791k, being the midpoint in the range with a minimum of £619k and maximum of £964k. Our closing free reserves position is £936k; overall this is £207k less than the prior year.
The Trustees are confident that the Charity remains a going concern and that there are no reasonably foreseeable material uncertainties within the next 12 months that would endanger our ability to continue operating and paying liabilities as they fall due.
The Trustees have the power to invest in such assets as they see fit. In 2016-17, the Trustees invested £500k of the reserves with Sarasin & Partners in a multi-asset, multi-market portfolio, recognising their responsibility to make the assets of the Charity work as effectively as possible. This is seen as a long-term investment. Foster Denovo were appointed as investment advisers. The investment was made in 2016 and has been overseen since then by the Investment SubCommittee of the Board. During 2024-25, the value of these investments increased to a value of £778k at March 2025.
During 2024-25, the majority of cash was held in interest bearing accounts; the yield on which was 1.8% for the year.
The Board has an Audit and Risk Committee comprising five Trustees with the Chief Executive and Head of Finance in attendance. The Committee formally reviews and updates the Charity’s operational and strategic risk register at twice yearly meetings. Risk is also discussed regularly by the Senior Leadership Team and contemporaneous risks/issues requiring management attention are reported to the Board using the quarterly KPI Dashboard.
The risk environment elevated in 2024-25, as the charity faced a challenging economic environment and associated challenges in fundraising and income generation. In particular, the worse than expected financial outturn in 2024-25 has impacted negatively upon the charity’s balance sheet, limiting the financial headroom that the charity has benefited from as it has sought to recover and rebuild following the Covid-19 pandemic. This limitation exacerbates income risks; hence, the charity has refocussed its financial plans for 2025-26 and beyond in order to realign income and expenditure budgets, whilst proactively seeking savings/efficiencies and exploring opportunities to invest and grow income.
In 2025-26, we anticipate the following risks:
1. Income growth. A challenging end to the 2024-25 year, coupled with a difficult economic environment, lead to the risk around income growth being elevated. The charity has always been sensitive to income risks and hence has, in recent years, planned on both a short- and long-term basis. Income risks are similarly judged to be both short-term (e.g. an uncontrollable event affecting the London Marathon or a global-financial shock) and medium- and long-term (e.g. the failure to plan effectively for growth). Awareness of these risks ensures the charity actively monitors and manages its finances as well as its fundraising capacity and capabilities.
2. Cyber security and data protection. As reported over the last several years, Meningitis Now has significantly enhanced its cyber security through adopting defence systems and upgrading to cloud-based software. This is recognised by the charity being award the Cyber Essentials Plus accreditation. Unfortunately, ever-changing digital risk environment means that we can never guarantee total protection from a cyber/data security breach which could, in turn, prove operationally, financially and reputationally damaging.
3. Workforce risks and change management. Since the Covid-19 pandemic forced the charity to restructure and downsize, the charity has grown its staffing establishment in line with its strategic, operational and financial plans. With risks around income growth and the economic environment escalating, the charity will need to take a more cautious approach and adapt its operational activities accordingly. This can entail challenges of change management, such as the pace and nature of change and how to adapt organisational and staff development accordingly.
We consider that reasonable mitigations or plans are in place to address these principal risks, as well others identified in the charity’s Risk Register.
The Trustees (who are also Directors of Meningitis Now for the purposes of company law) are responsible for preparing the Trustees’ report and the financial statements in accordance with applicable law and United Kingdom Accounting Standards (United Kingdom Generally Accepted Accounting Practice).
Company law requires the Trustees to prepare financial statements for each financial year, which give a true and fair view of the state of affairs of the charitable company and the group and of the incoming resources and application of resources, including the income and expenditure, of the charitable company/group for that period. In preparing these financial statements, the Trustees are required to:
• Select suitable accounting policies and then apply them consistently
• Observe the methods and principles in the Charities SORP
• Make judgements and estimates that are reasonable and prudent
• State whether applicable UK Accounting Standards have been followed, subject to any material departures disclosed and explained in the financial statements
• Prepare the financial statements on the going concern basis unless it is inappropriate to presume that the charitable company will continue in operation.
The Trustees are responsible for keeping adequate accounting records that disclose with reasonable accuracy at any time the financial position of the charitable company and enable them to ensure that the financial statements comply with the Companies Act 2006, the Charities and Trustee Investment (Scotland) Act 2005 and the Charities Accounts (Scotland) Regulations 2006 (as amended). They are also responsible for safeguarding the assets of the charitable company and the group, hence taking reasonable steps for the prevention and detection of fraud and other irregularities.
In so far as the Trustees are aware:
• There is no relevant audit information of which the charitable company’s auditors are unaware.
• The Trustees have taken all steps that they ought to have taken to make themselves aware of any relevant audit information and to establish that the auditors are aware of that information.
The Trustees are responsible for the maintenance and integrity of the corporate and financial information included on the charitable company's website. Legislation in the United Kingdom governing the preparation and dissemination of financial statements may differ from legislation in other jurisdictions.
The Trustees, who are also directors under company law, who served during the year and up to the date of this report, were as follows:
Mr R Adlington
Mrs S Blackie (resigned, October 2024)
Ms H Byrne
Professor S Kroll
Miss H Marsh, Treasurer
Mrs J Marsh
Mr C Philipsborn, Chair
Mrs Richardson
Mr S Sutcliffe
Mr J Sutherland, Vice Chair
Ms E Thomas, Deputy Treasurer
Mr R Weeks
The Trustees operate a Nominations Committee. This committee is made up of four Trustees and the Chief Executive in attendance. This committee is responsible for overseeing the skills mix of the Board and recruitment of new Trustees. No new Trustees were appointed in 2024-25.
Members of the charitable company guarantee to contribute an amount not exceeding £1 to the assets of the charitable company in the event of winding up. The total number of such guarantees at 31 March 2025 was 43 (2024 – 44).
The Trustees have no beneficial interest in the group or charitable company
Sayer Vincent were reappointed as auditors during the year and have expressed their willingness to continue in that capacity.
The report of the Trustees has been prepared in accordance with the special provisions applicable to companies subject to the small companies' regime.
Approved by the Trustees on 25th September 2025 and signed on their behalf by

Christopher
Philipsborn
- Chair of the Board of Trustees
Status
Governing document
The organisation is a charitable company limited by guarantee, incorporated on 12 February 1990 and registered as a charity in England and Wales on 9 March 1990. On 7 February 2007, the Charity was registered with the Office of the Scottish Regulator (OSCR).
The organisation was established under a Memorandum of Association, which established the objects and powers of the organisation and is governed under its Articles of Association, which were last updated in October 2022.
Company number 2469130
Charity numbers
Registered office and operational address
Trustees
803016 England & Wales
SC037790 Scotland
Fern House, Bath Road, Stroud, Gloucestershire GL5 3TJ
Mr R Adlington
Mrs S Blackie (resigned October 2024)
Ms H Byrne
Professor S Kroll
Miss H Marsh, Treasurer
Mrs J Marsh
Mr C Philipsborn, Chair
Mrs Richardson
Mr S Sutcliffe
Mr J Sutherland, Vice Chair
Ms E Thomas, Deputy Treasurer
Mr R Weeks
President Lisa Snowdon
Principal staff
Honorary Medical Director
Scientific & Medical Advisory Panel
Royal Patron
Dr Thomas Nutt, Chief Executive Officer
Professor Simon Kroll MA, BM, BCh, FRCPCH, FRCP, FMedSci
Dr Caroline Vipond PhD (Senior Scientific Advisor)
Professor Simon Kroll
Dr Xilian Bai PhD
Dr Darryl Hill BSc, PhD (Wales)
HRH The Duchess of Edinburgh GCVO
Patrons & Ambassadors
Dr Tim Brain OBE, QPM, BA, PhD, FRSA, CCMI
Dr Ellie Cannon
Baroness Corston
Professor the Lord Darzi of Denham KBE, OM, HonFrEng, FMedSci
Petra Ecclestone
Andrew Harvey
Julie Hesmondhalgh
Dr Robert Hicks
Seema Jaswal
Denis Law CBE (died January 2025)
Ken Loach
Dr Mark Porter MBE
Tana Ramsay
Ian Rush MBE
Dr Ranj Singh
Geoff Shaw
Lisa Snowdon
Dr Chris Steele MBE
Joanna Trollope OBE
Dr Jane Wells MBE
Rt Rev. and the Rt Hon. The Lord Williams of Oystermouth
We have audited the financial statements of Meningitis Now (the ‘parent charitable company’) and its subsidiary (the ‘group’) for the year ended 31 March 2025 which comprise the consolidated statement of financial activities, the group and parent charitable company balance sheets, the consolidated statement of cash flows and the notes to the financial statements, including significant accounting policies. The financial reporting framework that has been applied in their preparation is applicable law and United Kingdom Accounting Standards, including FRS 102 The Financial Reporting Standard applicable in the UK and Republic of Ireland (United Kingdom Generally Accepted Accounting Practice).
In our opinion, the financial statements:
● Give a true and fair view of the state of the group’s and of the parent charitable company’s affairs as at 31 March 2025 and of the group’s incoming resources and application of resources, including its income and expenditure, for the year then ended
● Have been properly prepared in accordance with United Kingdom Generally Accepted Accounting Practice
● Have been prepared in accordance with the requirements of the Companies Act 2006, the Charities and Trustee Investment (Scotland) Act 2005 and regulations 6 and 8 of the Charities Accounts (Scotland) Regulation 2006 (as amended)
We conducted our audit in accordance with International Standards on Auditing (UK) (ISAs (UK)) and applicable law. Our responsibilities under those standards are further described in the auditor’s responsibilities for the audit of the financial statements section of our report. We are independent of the group in accordance with the ethical requirements that are relevant to our audit of the financial statements in the UK, including the FRC’s Ethical Standard, and we have fulfilled our other ethical responsibilities in accordance with these requirements. We believe that the audit evidence we have obtained is sufficient and appropriate to provide a basis for our opinion.
In auditing the financial statements, we have concluded that the trustees' use of the going concern basis of accounting in the preparation of the financial statements is appropriate.
Based on the work we have performed, we have not identified any material uncertainties relating to events or conditions that, individually or collectively, may cast significant doubt on Meningitis Now's ability to continue as a going concern for a
period of at least twelve months from when the financial statements are authorised for issue.
Our responsibilities and the responsibilities of the trustees with respect to going concern are described in the relevant sections of this report.
The other information comprises the information included in the trustees’ annual report, other than the financial statements and our auditor’s report thereon. The trustees are responsible for the other information contained within the annual report. Our opinion on the financial statements does not cover the other information and, except to the extent otherwise explicitly stated in our report, we do not express any form of assurance conclusion thereon.
Our responsibility is to read the other information and, in doing so, consider whether the other information is materially inconsistent with the financial statements or our knowledge obtained in the course of the audit or otherwise appears to be materially misstated. If we identify such material inconsistencies or apparent material misstatements, we are required to determine whether this gives rise to a material misstatement in the financial statements themselves. If, based on the work we have performed, we conclude that there is a material misstatement of this other information, we are required to report that fact.
We have nothing to report in this regard.
In our opinion, based on the work undertaken in the course of the audit:
● The information given in the trustees’ annual report, for the financial year for which the financial statements are prepared is consistent with the financial statements
● The trustees’ annual report, has been prepared in accordance with applicable legal requirements
In the light of the knowledge and understanding of the group and the parent charitable company and its environment obtained in the course of the audit, we have not identified material misstatements in the trustees’ annual report.
We have nothing to report in respect of the following matters in relation to which the Companies Act 2006 and Charities Accounts (Scotland) Regulations 2006 (as amended) requires us to report to you if, in our opinion:
● Adequate accounting records have not been kept by the parent charitable company, or returns adequate for our audit have not been received from branches not visited by us; or
● The parent charitable company financial statements are not in agreement with the accounting records and returns; or
● Certain disclosures of trustees’ remuneration specified by law are not made; or
● We have not received all the information and explanations we require for our audit; or
● The directors were not entitled to prepare the financial statements in accordance with the small companies regime and take advantage of the small companies’ exemptions in preparing the trustees’ annual report and from the requirement to prepare a strategic report.
As explained more fully in the statement of trustees’ responsibilities set out in the trustees’ annual report, the trustees (who are also the directors of the parent charitable company for the purposes of company law) are responsible for the preparation of the financial statements and for being satisfied that they give a true and fair view, and for such internal control as the trustees determine is necessary to enable the preparation of financial statements that are free from material misstatement, whether due to fraud or error.
In preparing the financial statements, the trustees are responsible for assessing the group’s and the parent charitable company’s ability to continue as a going concern, disclosing, as applicable, matters related to going concern and using the going concern basis of accounting unless the trustees either intend to liquidate the group or the parent charitable company or to cease operations, or have no realistic alternative but to do so.
We have been appointed as auditor under section 44(1)(c) of the Charities and Trustee Investment (Scotland) Act 2005 and under the Companies Act 2006 and report in accordance with regulations made under those Acts.
Our objectives are to obtain reasonable assurance about whether the financial statements as a whole are free from material misstatement, whether due to fraud or error, and to issue an auditor’s report that includes our opinion. Reasonable assurance is a high level of assurance, but is not a guarantee that an audit conducted in accordance with ISAs (UK) will always detect a material misstatement when it exists. Misstatements can arise from fraud or error and are considered material if, individually or in the aggregate, they could reasonably be expected to influence the economic decisions of users taken on the basis of these financial statements.
Irregularities, including fraud, are instances of non-compliance with laws and regulations. We design procedures in line with our responsibilities, outlined above, to detect material misstatements in respect of irregularities, including fraud. The extent
to which our procedures are capable of detecting irregularities, including fraud are set out below.
In identifying and assessing risks of material misstatement in respect of irregularities, including fraud and non-compliance with laws and regulations, our procedures included the following:
● We enquired of management and the audit and risk committee, which included obtaining and reviewing supporting documentation, concerning the group’s policies and procedures relating to:
● Identifying, evaluating, and complying with laws and regulations and whether they were aware of any instances of non-compliance;
● Detecting and responding to the risks of fraud and whether they have knowledge of any actual, suspected, or alleged fraud;
● The internal controls established to mitigate risks related to fraud or noncompliance with laws and regulations.
● We inspected the minutes of meetings of those charged with governance.
● We obtained an understanding of the legal and regulatory framework that the group operates in, focusing on those laws and regulations that had a material effect on the financial statements or that had a fundamental effect on the operations of the group from our professional and sector experience.
● We communicated applicable laws and regulations throughout the audit team and remained alert to any indications of non-compliance throughout the audit.
● We reviewed any reports made to regulators.
● We reviewed the financial statement disclosures and tested these to supporting documentation to assess compliance with applicable laws and regulations.
● We performed analytical procedures to identify any unusual or unexpected relationships that may indicate risks of material misstatement due to fraud.
● In addressing the risk of fraud through management override of controls, we tested the appropriateness of journal entries and other adjustments, assessed whether the judgements made in making accounting estimates are indicative of a potential bias and tested significant transactions that are unusual or those outside the normal course of business.
Because of the inherent limitations of an audit, there is a risk that we will not detect all irregularities, including those leading to a material misstatement in the financial statements or non-compliance with regulation. This risk increases the more that compliance with a law or regulation is removed from the events and transactions reflected in the financial statements, as we will be less likely to become aware of instances of non-compliance. The risk is also greater regarding irregularities occurring due to fraud rather than error, as fraud involves intentional concealment, forgery, collusion, omission or misrepresentation.
A further description of our responsibilities is available on the Financial Reporting Council’s website at: www.frc.org.uk/auditorsresponsibilities. This description forms part of our auditor’s report.
This report is made solely to the charitable company's members as a body, in accordance with Chapter 3 of Part 16 of the Companies Act 2006 and section 44(1)(c) of the Charities and Trustee Investment (Scotland) Act 2005. Our audit work has been undertaken so that we might state to the charitable company's members those matters we are required to state to them in an auditor’s report and for no other purpose. To the fullest extent permitted by law, we do not accept or assume responsibility to anyone other than the charitable company and the charitable company's members as a body, for our audit work, for this report, or for the opinions we have formed.

Jonathan Orchard (Senior statutory auditor)
7 October 2025 for and on behalf of Sayer Vincent LLP, Statutory Auditor 110 Golden Lane, LONDON, EC1Y 0TG
Sayer Vincent LLP is eligible to act as auditor in terms of section 1212 of the Companies Act 2006
Meni ngi ti s Now
Consol i dated statement of f i nanci al acti vi ti es (incorporating an income and expenditure account)
For the year ended 31 March 2025
Donations and legacies
Charitable activities
Support
Comms & Awareness
Advocacy & Engagement
Knowledge & Info Sharing
Research
Other trading activities
Fundraising events
Other income
Investments - interest on bank deposits
Total i ncome
Expendi ture on:
Raising funds
Donations and legacies
Fundraising events
Charitable activities
Support Comms & Awareness
Advocacy & Engagement
Knowledge & Info Sharing Research
Total expendi ture
Transf ers between f unds
Net i ncome / (expendi ture) bef ore net gai ns on i nvestments
Net (losses)/gains on investments
Net movement i n f unds
Total funds brought forward
Total f unds carri ed f orward
All of the above results are derived from continuing activities. There were no other recognised gains or losses other than those stated above. Movements in funds are disclosed in Note 17a to the financial statements.
Ba la nce sheets Company no.
As a t 31 Ma r ch 2025
The gr oup
Tangible assets
Investments
Debtors
Cash at bank and in hand
Creditors: amounts falling due within one year
Net cur r ent a ssets / (lia bilities)
Tota l a ssets less cur r ent lia bilities
Tota l net a ssets / (lia bilities)
Funds:
Restricted income funds
Unrestricted income funds: General funds
Tota l funds
These accounts have been prepared in accordance with the special provisions applicable to small companies subject to the small companies' regime.
Approved by the trustees on 25 September 2025 and signed on their behalf by

Chairman Christopher Philipsborn
Consolida ted sta tement of ca sh flows
For the yea r ended 31 Ma r ch 2025
Reconcilia tion of net income / (expenditur e) to net ca sh flow fr om oper a ting a ctivities
Net (expenditur e) / income for the r epor ting per iod (a s per the sta tement of fina ncia l a ctivities)
Net ca sh pr ovided by oper a ting a ctivities
Ca sh flows fr om oper a ting a ctivities
Net ca sh (used in) oper a ting a ctivities
Ca sh flows fr om investing a ctivities: Dividends and interest Purchase of fixed assets Movement in investment cash
Net ca sh pr ovided by / (used in) investing a ctivities
Cash and cash equivalents at the beginning of the year
(479,080) (188,385) 1 1,155,265 1,343,650 6 676,185 1,155,265
Notes to the financial statements
F or the y ear ended 31 Mar ch 2025
Meningitis Now is a charitable company limited by guarantee and is incorporated in United Kingdom. The registered office address and principal place of business is Fern House, Bath Road, Gloucester, GL5 3TJ.
The financial statements have been prepared in accordance with Accounting and Reporting by Charities: Statement of Recommended Practice applicable to charities preparing their accounts in accordance with the Financial Reporting Standard applicable in the UK and Republic of Ireland (FRS 102) (effective 1 January 2019) - (Charities SORP FRS 102), the Financial Reporting Standard applicable in the UK and Republic of Ireland (FRS 102) (March 2018) and the Companies Act 2006.
Assets and liabilities are initially recognised at historical cost or transaction value unless otherwise stated in the relevant accounting policy or note.
These financial statements consolidate the results of the charitable company and its wholly-owned subsidiary Meningitis Trust Trading Limited, over which the charity has control through membership, on a line by line basis. Transactions and balances between the charitable company and its subsidiary have been eliminated from the consolidated financial statements. Balances between the companies are disclosed in the notes of the charitable company's balance sheet. A separate statement of financial activities, or income and expenditure account, for the charitable company itself is not presented because the charitable company has taken advantage of the exemptions afforded by section 408 of the Companies Act 2006.
Public benefit entity
The charitable company meets the definition of a public benefit entity under FRS 102.
G oing concer n
The trustees consider that there are no material uncertainties about the charitable company's ability to continue as a going concern. In making this statement, the trustees have completed financial projections through to March 2025 including cash and reserves.
The trustees do not consider that there are any sources of estimation uncertainty at the reporting date that have a significant risk of causing a material adjustment to the carrying amounts of assets and liabilities within the next reporting period.
Income is recognised when the charity has entitlement to the funds, any performance conditions attached to the income have been met, it is probable that the income will be received and that the amount can be measured reliably.
Income from grants is recognised when the charity has entitlement to the funds, any performance conditions attached to the grants have been met, it is probable that the income will be received and the amount can be measured reliably and is not deferred.
For legacies, entitlement is taken as the earlier of the date on which either: the charity is aware that probate has been granted, the estate has been finalised and notification has been made by the executor(s) to the charity that a distribution will be made, or when a distribution is received from the estate. Receipt of a legacy, in whole or in part, is only considered probable when the amount can be measured reliably and the charity has been notified of the executor’s intention to make a distribution. Where legacies have been notified to the charity, or the charity is aware of the granting of probate, and the criteria for income recognition have not been met, then the legacy is a treated as a contingent asset and disclosed if material.
Income from fundraising events is recognised in the period in which it is received, except where it is refundable. Where it is refundable, income is retained on the balance sheet and only released when the obligation to refund is no longer applicable. Where expenditure is incurred for an event in a future year, it is expensed to the accounts of the year in which the legal obligation arises.
Income from trading activities is the income from the Charity's trading subsidiary which is transferred to the Charity by way of a gift in accordance with a profit shedding agreement between the Charity and its subsidiary.
Income received in advance of the provision of a specified service is deferred until the criteria for income recognition are met.
Donations of gifts, ser vices and facilities
Donated professional services and donated facilities are recognised as income when the charity has control over the item or received the service, any conditions associated with the donation have been met, the receipt of economic benefit from the use by the charity of the item is probable and that economic benefit can be measured reliably.
On receipt, donated gifts, professional services and donated facilities are recognised on the basis of the value of the gift to the charity which is the amount the charity would have been willing to pay to obtain services or facilities of equivalent economic benefit on the open market; a corresponding amount is then recognised in expenditure in the period of receipt.
Accounting policies (continued)
Inter est r eceivable
Interest on funds held on deposit is included when receivable and the amount can be measured reliably by the charity; this is normally upon notification of the interest paid or payable by the bank.
F und a ccounting
Restricted funds are to be used for specific purposes as laid down by the donor. Expenditure which meets these criteria is charged to the fund.
Unrestricted funds are donations and other incoming resources received or generated for the charitable purposes.
Designated funds are unrestricted funds earmarked by the trustees for particular purposes.
Expenditur e and ir r ecover able VAT
Expenditure is recognised once there is a legal or constructive obligation to make a payment to a third party, it is probable that settlement will be required and the amount of the obligation can be measured reliably. Expenditure is classified under the following activity headings:
Costs of raising funds relate to the costs incurred by the charitable company in inducing third parties to make voluntary contributions to it, as well as the cost of any activities with a fundraising purpose
Expenditure on charitable activities includes the costs of communication and education, community support, the helpline and supports grants undertaken to further the purposes of the charity and their associated support costs
Other expenditure represents those items not falling into any other heading
Irrecoverable VAT is charged as a cost against the activity for which the expenditure was incurred.
Resources expended are allocated to the particular activity where the cost relates directly to that activity. However, the cost of overall direction and administration of each activity, comprising the salary and overhead costs of the central function, is apportioned on the following basis which are an estimate, based on staff time, of the amount attributable to each activity.
Fundraising
Support
Communication and awareness
Advocacy & Engagement
Knowledge & Info Sharing
Research
Support and governance costs are re-allocated to each of the activities on the following basis which is an estimate, based on staff time, of the amount attributable to each activity. 33.7%
Fundraising
Support
Communication and awareness
Advocacy & Engagement
Knowledge & Info Sharing
Research
Governance costs are the costs associated with the governance arrangements of the charity. These costs are associated with constitutional and statutory requirements and include any costs associated with the strategic management of the charity’s activities.
G rants pay able
Financial Support Grants (i.e. Rebuilding Futures Fund) payable are accounted for in the period in which the award is communicated to the recipient, and becomes a contractual commitment. Research Grants are recognised as they become contractually due which is on production of acceptable progress reports or a final report at the end of the research project.
Oper ating leases
Rental charges are charged on a straight line basis over the term of the lease.
Accounting policies (continued)
Tangible fixed assets
Items of equipment are capitalised where the purchase price exceeds £300. Depreciation costs are allocated to activities on the basis of the use of the related assets in those activities. Assets are reviewed for impairment if circumstances indicate their carrying value may exceed their net realisable value and value in use.
Where fixed assets have been revalued, any excess between the revalued amount and the historic cost of the asset will be shown as a revaluation reserve in the balance sheet.
Depreciation is provided at rates calculated to write down the cost of each asset to its estimated residual value over its expected useful life. The depreciation rates in use are as follows:
Office & computer equipment
Furniture
Motor Vehicles
Listed investments
25% per annum on cost
15% per annum on cost
33% per annum on cost
Investments are a form of basic financial instrument and are initially recognised at their transaction value and subsequently measured at their fair value as at the balance sheet date using the closing quoted market price. Investment gains and losses, whether realised or unrealised, are combined and shown in the heading “Net gains/(losses) on investments” in the statement of financial activities. The charity does not acquire put options, derivatives or other complex financial instruments.
Investments in subsidiar ies
Investments in subsidiaries are at cost.
Debtor s
Trade and other debtors are recognised at the settlement amount due after any trade discount offered. Prepayments are valued at the amount prepaid net of any trade discounts due.
Cash at bank and in hand
Cash at bank and cash in hand includes cash and short term highly liquid investments with a short maturity of three months or less from the date of acquisition or opening of the deposit or similar account. Cash balances exclude any funds held on behalf of service users.
Cr editors and pr ovisions
Creditors and provisions are recognised where the charity has a present obligation resulting from a past event that will probably result in the transfer of funds to a third party and the amount due to settle the obligation can be measured or estimated reliably. Creditors and provisions are normally recognised at their settlement amount after allowing for any trade discounts due.
F inancial instr uments
The charity only has financial assets and financial liabilities of a kind that qualify as basic financial instruments. Basic financial instruments are initially recognised at transaction value and subsequently measured at their settlement value.
F or eign exchange
Transactions in foreign currencies are translated at the average exchange rate for the period. Balances denominated in foreign currencies are translated at the rate of exchange prevailing at the balance sheet date.
Pensions
The charity operates a defined contribution pension scheme. The assets of the scheme are held separately from those of the charity in an independently administered fund. The pension cost charge represents contributions payable under the scheme by the charity to the fund. The charity has no liability under the scheme other than for the payment of those contributions.
Income fr om dona tions and legacies
Legacies
Donated services
Community fundraising
Other donations
Gifts in kind comprise mainly pro bono advertising services and awareness campaign support.
Income fr om char itable a ctivities
Other Income for Support
Sub Total for Support
Other income for Comms & Awareness
Sub-total for Comms & Awareness
Sub-total for Advocacy & Engagement
Sub-total for Knowledge & Info Sharing
Other income from research
Sub-total for research
Total income from charitable activities
For the y ea r ended 31 M a rch 2025 Notes to the fi na nci a l sta tements
Gra nt ma ki ng (current y ea r)
Cost/ (reca l l of a mounts)
University of Bristol - PhD Studentship London School H&TP- Prof. Basu Roy
UCL - Prof.Brown
Imperial College London - Prof. Wilkinson
At the end of the year
The governance costs allocated for 2024/25 totalled £711 (2023/24 £608). These are described in detail in Note 4.
Commi tments
Commitments in respect of grants for approved projects which have not been accrued in the accounts:
These commitments are not recognised as expenditure in the year as payments are subject to reviews of project progress by Meningitis Now.
Gra nt ma ki ng (pri or y ea r)
Cost
University of Bristol - PhD Studentship London School H&TP- Prof. Basu Roy UCL - Prof.Brown
Commissioned Research - Picker Institute Europe University of Liverpool - Prof.Kadioglu
Imperial College London - Prof. Wilkinson
At the end of the year
Net i ncomi ng resources for the y ea r
This is stated after charging / crediting:
Depreciation
Operating lease rentals: Other
Auditors' remuneration (excluding VAT): Audit
Other services
Ana l y si s of sta ff costs, trustee remunera ti on a nd expenses, a nd the cost of key ma na gement personnel
Staff costs were as follows:
Social security costs
Employer’s contribution to defined contribution pension schemes
1 employee earned between £60,000 and £70,000 during the year (2023/24: 1). 0 employee earned between £70,000 and £80,000 in the year (2023/24: 0). 1 employee earned between £80,000 and £90,000. 0 employee earned between £90,000 and £100,000 in the year (2023/24: 0).
The total employee benefits including pension contributions and national insurance of the key management personnel were £261,154 (2023/24: £262,791).
The charity trustees were not paid or received any other benefits from employment with the charity in the year (2024: £nil). No charity trustee received payment for professional or other services supplied to the charity (2024: £nil).
Trustees' expenses represents the payment or reimbursement of travel and subsistence costs totalling £33 (2024: £nil).
S ta ff numbers
The average number of employees (head count based on number of staff employed) during the year was as follows:
funds
Support Comms & Awareness
Advocacy & Engagement
Knowledge & Info Sharing
Research
The average number of Full Time Equivalent employees (based on number of staff employed) during the year was as follows:
Raising funds
Knowledge & Info Sharing
There are no donations from related parties which are outside the normal course of business and no restricted donations from related parties.
Ta xa ti on
The charity is exempt from corporation tax as all its income is charitable and is applied for charitable purposes. The charity's trading subsidiary Meningitis Trust Trading Limited gift aids available profits to the parent charity. Its charge to corporation tax in the year was:
UK corporation tax at 19% (2024: 19%)
ngi bl e fi xed a ssets
The group a nd cha ri ty
Cost
At the start of the year
Additions in year
Disposals in year
At the end of the year
At the start of the year Charge for the year
Eliminated on disposal
At the end of the year
Depreci a ti on Net book va l ue
At the end of the y ea r
At the start of the year
All of the above assets are used for charitable purposes.
Li sted i nvestments
Fair value at the start of the year
Additions at cost
Disposal proceeds
Net gain/loss on change in fair value
Cash held by investment broker pending reinvestment
Fair value at the end of the year
The charity only also holds £2 (2024: £2) of shares in the Meningitis Trust Trading.
For the y ea r ended 31 M a rch 2025
S ubsi di a ry underta ki ng
The charitable company owns the whole of the issued ordinary share capital of Meningitis Trust Trading Limited which is registered in England. The subsidiaries are used for non-primary purpose trading activities. All activities have been consolidated on a line by line basis in the statement of financial activities. Available profits are gift aided to the charitable company. A summary of the results of the Meningitis Trust Trading Limited is shown below:
Cost of sales
Gross profit
Administrative expenses Turnover Operating profit / (loss)
Deed of covenant to parent undertaking
Profit / (loss) for the financial year
The aggregate of the assets, liabilities and funds was:
Liabilities
P a rent cha ri ty
The parent charity's gross income and the results for the year are disclosed as follows:
Gross income Result for the year
Debtors
Trade debtors
Prepayments
Accrued income and other debtors
For the y ea r ended 31 M a rch 2025 Notes to the fi na nci a l sta tements 17a
M ovements i n funds (current y ea r)
17b
Restri cted funds
Support
Comms & Awareness
Advocacy & Engagement
Knowledge & Info Sharing
Research
Unrestri cted funds: Fundraising
Tota l unrestri cted funds
Tota l funds
Support - provision of support services for individuals and families including financial awards Comms and Awareness - general meningitis awareness raising Advocacy & Engagement - increasing awareness of the impact of meningitis and reaching more people needing support
Knowledge & Info Sharing - sharing knowledge to improve aftercare available for people affected by meningitis
Research - projects related to the prevention, treatment and outcomes of meningitis
Transfers -
£16,000 was moved from research to communications for use on a student campaign as agreed by the funder.
£40,000 was moved from research to support for use on a support services as agreed by the funder.
M ovements i n funds (pri or y ea r)
Restri cted funds:
Support Comms & Awareness Advocacy & Engagement
Knowledge & Info Sharing
Research Fundraising
Unrestri cted funds:
Tota l unrestri cted funds
Tota l funds
For the y ea r ended 31 M a rch 2025
Purposes of restricted funds
Support - provision of support services including grants for beneficiaries
Comms and Awareness - General meningitis awareness raising Knowledge & Info Sharing - sharing knowledge to improve aftercare available for people affected by meningitis
Advocacy & Engagement - increasing awareness of the impact of meningitis and reaching more people needing support
Research - projects related to the prevention, treatment and outcomes of meningitis Transfers
£23,336 was moved from research to communications for use on a student campaign as agreed by the funder. £13,500 transfer from prior year unrestricted to research as omitted.
£13,409 was transferred from restricted to unrestricted with agreement with the funders in light of Covid-19.
Opera ting lea se commitments
The group and the charity's total future minimum lease payments under non-cancellable operating leases is as follows for each of the following periods:
Less than one year One to five years
Lega l sta tus of the cha rity
The charity is a company limited by guarantee and has no share capital. The liability of each member in the event of winding up is limited to £1.
Meningitis Now is the UK’s leading meningitis charity, committed to the fight against meningitis. We save lives and rebuild futures by funding research, raising awareness and providing support for people whose lives have been affected by meningitis.
Help us save lives and rebuild futures today by:
• Making a donation
• Taking part in an event
• Posting and sharing our content on social media
• Volunteering your time
• Sharing your story
Visit www.MeningitisNow.org and help us make a difference, every day.
Contact us on
Phone: 01453 768000
Nurse-led Helpline: 0808 80 10 388 (9am-4pm Monday – Thursday and 9am-1pm Friday)
Email: info@meningitisnow.org
Social media:
fb.com/meningitisnow @MeningitisNow @meningitis_now @meningitisnow @meningitis-now
Meningitis Now Fern House Bath Road Stroud Gloucestershire
GL5 3TJ